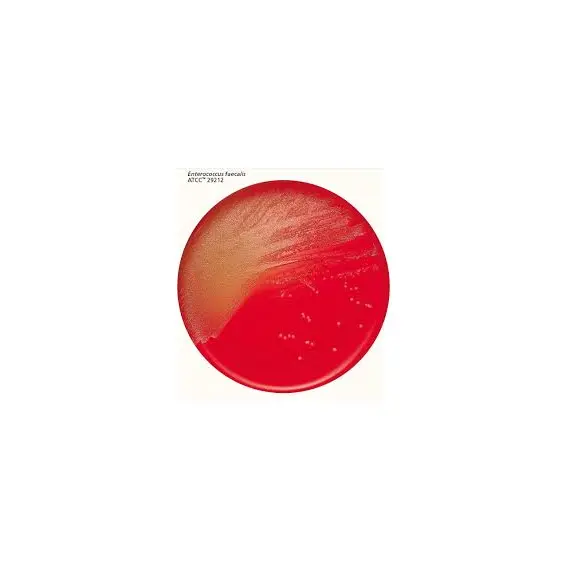

COLUMBIA CNA AGAR Pl-25ml
344
التوصيل
خيارات الدفع
مميزاتنا
- — توصيل سريع
- — اشعارات الايميل
- — طرق دفع مختلفة
- — اسعار تنافسية
Find similar
Features
Reviews
لم يتم العثور على أي تقييمات
الرجاء تسجيل الدخول حتى نتمكن من إخطارك بالرد